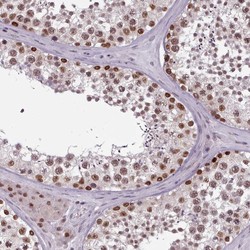

Antibody data
- Antibody Data
- Antigen structure
- References [0]
- Comments [0]
- Validations
- Western blot [1]
- Immunocytochemistry [1]
- Immunohistochemistry [4]
Submit
Validation data
Reference
Comment
Report error
- Product number
- HPA049849 - Provider product page

- Provider
- Atlas Antibodies
- Proper citation
- Atlas Antibodies Cat#HPA049849, RRID:AB_2680911
- Product name
- Anti-SRSF9
- Antibody type
- Polyclonal
- Reactivity
- Human
- Host
- Rabbit
- Conjugate
- Unconjugated
- Antigen sequence
PRTYGGRGGWPRGGRNGPPTRRSDF- Isotype
- IgG
- Vial size
- 100 µl
- Storage
- Store at +4°C for short term storage. Long time storage is recommended at -20°C.
No comments: Submit comment
Supportive validation
- Submitted by
- Atlas Antibodies (provider)
- Main image

- Experimental details
- Lane 1: Marker [kDa] 250, 130, 95, 72, 55, 36, 28, 17, 10Lane 2: Human cell line RT-4
Supportive validation
- Submitted by
- Atlas Antibodies (provider)
- Main image

- Experimental details
- Immunofluorescent staining of human cell line MCF7 shows localization to nucleoplasm & nucleoli.
- Sample type
- HUMAN
Enhanced validation
Supportive validation
- Submitted by
- Atlas Antibodies (provider)
- Enhanced method
- Orthogonal validation
- Main image

- Experimental details
- Immunohistochemistry analysis in human testis and skeletal muscle tissues using Anti-SRSF9 antibody. Corresponding SRSF9 RNA-seq data are presented for the same tissues.
- Sample type
- HUMAN
Supportive validation
- Submitted by
- Atlas Antibodies (provider)
- Main image

- Experimental details
- Immunohistochemical staining of human kidney shows strong nuclear and cytoplasmic positivity in cells in tubules.
- Submitted by
- Atlas Antibodies (provider)
- Main image
- Experimental details
- Immunohistochemical staining of human testis shows high expression.
- Sample type
- HUMAN
- Submitted by
- Atlas Antibodies (provider)
- Main image

- Experimental details
- Immunohistochemical staining of human skeletal muscle shows low expression as expected.
- Sample type
- HUMAN
 Explore
Explore Validate
Validate Learn
Learn Western blot
Western blot Immunohistochemistry
Immunohistochemistry